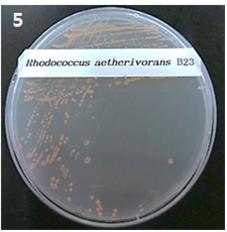

[환경일보] 한이삭 기자 = 환경오염물질을 분해하는 미생물이 발견돼 화제를 모으고 있다.
국립낙동강생물자원관(관장 안영희)은 ‘2016년 담수유래 유해물질 저감용 원천소재 개발사업’ 결과 낙동강 지류에서 특정수질유해물질인 페놀을 제거할 수 있는 미생물 13종을 발견했다고 밝혔다.
![]() |
페놀 및 BTEX 제거 기능이 있는 로도코커스 에쓰리보란스 B23균주 |
낙동강생물자원관 연구진은 이번에 발견한 미생물 13종의 페놀 제거 원리를 비롯해 유용효소 및 대사체 생산 등의 심화 연구를 진행 중이다. 또한 오염된 환경에서 페놀 제거효율이 높은 미생물을 선발하기 위한 페놀 제거효율 검증실험으로 실제 강물에서 이들 미생물 13종의 페놀 제거기능을 확인했다.
13종의 미생물 중 대표 균주인 로도코커스 에쓰리보란스 B23균주는 페놀 등 유해물질을 분해하는 능력이 뛰어난 것으로 알려져 있다. 로도코커스 에쓰리보란스 B23 균주(Rhodococcus aetherivorans B23)는 2008년 헝가리에서 유사종이 발견되어 연구된바 있으며 국내에서 로도코커스 에쓰리보란스 종을 연구하는 것은 최초 사례다.
이 균주는 페놀 이외 벤젠, 톨루엔 등 유해화학물질 6종을 총칭하는 ‘비티이엑스(BTEX)’까지도 제거하는 것으로 확인됐다.
안영희 국립낙동강생물자원관장은 “이번에 발견된 미생물들은 향후 환경오염물질 저감 미생물제제 개발 등 생물자원의 실증화를 위한 중요한 밑거름이 될 것”이라고 기대했다.
미생물 13종은 환경정화 소재로 활용하기 위해 미생물 효소의 페놀 제거효능, 유용미생물 혼합배양 등 유해물질 분해 최적화 연구 과정이 진행될 예정이다.